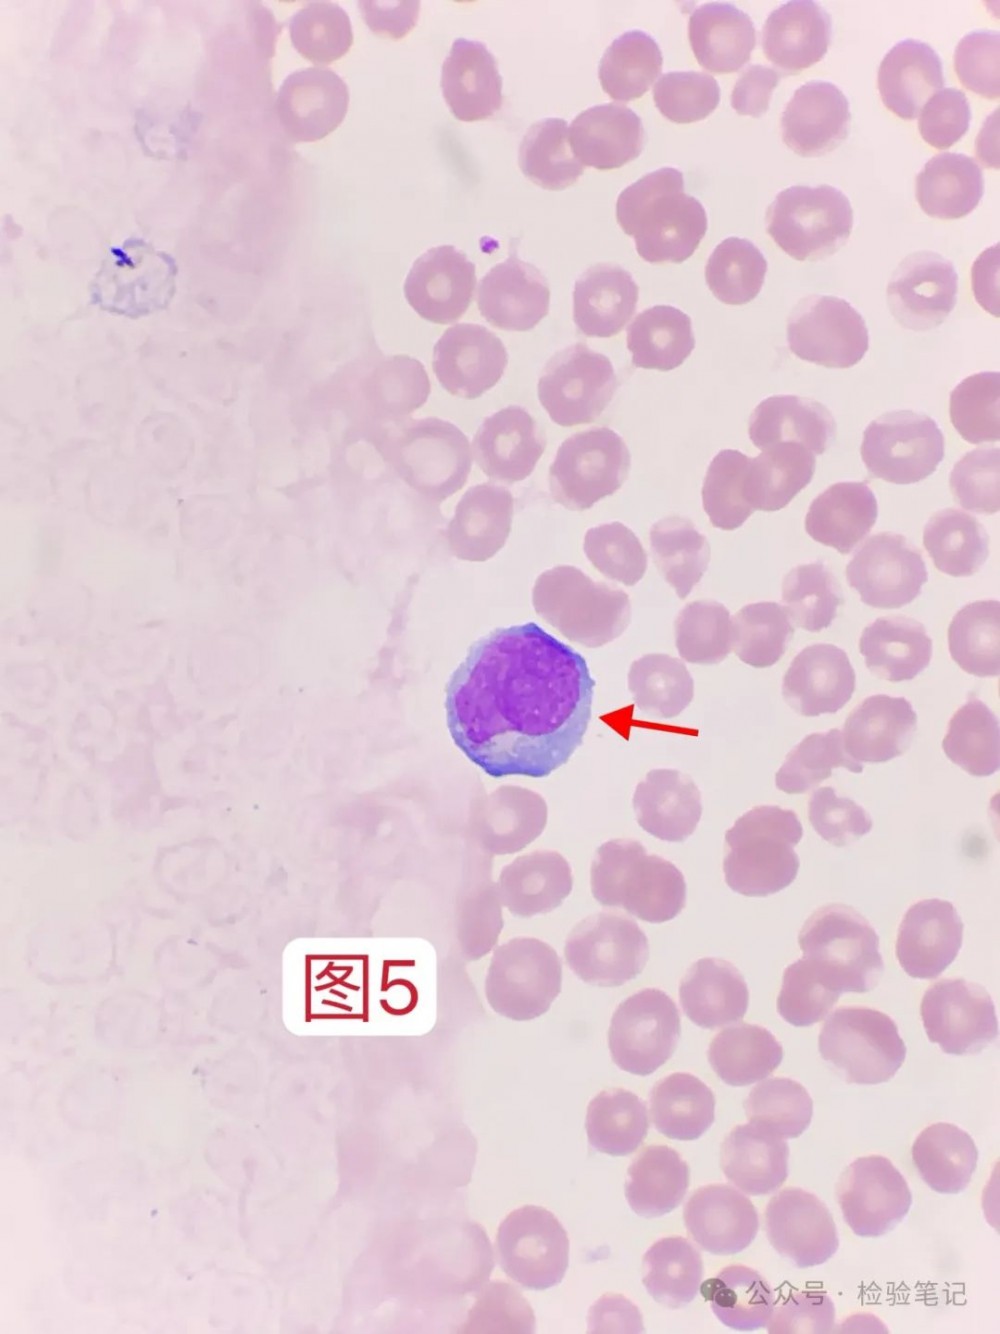
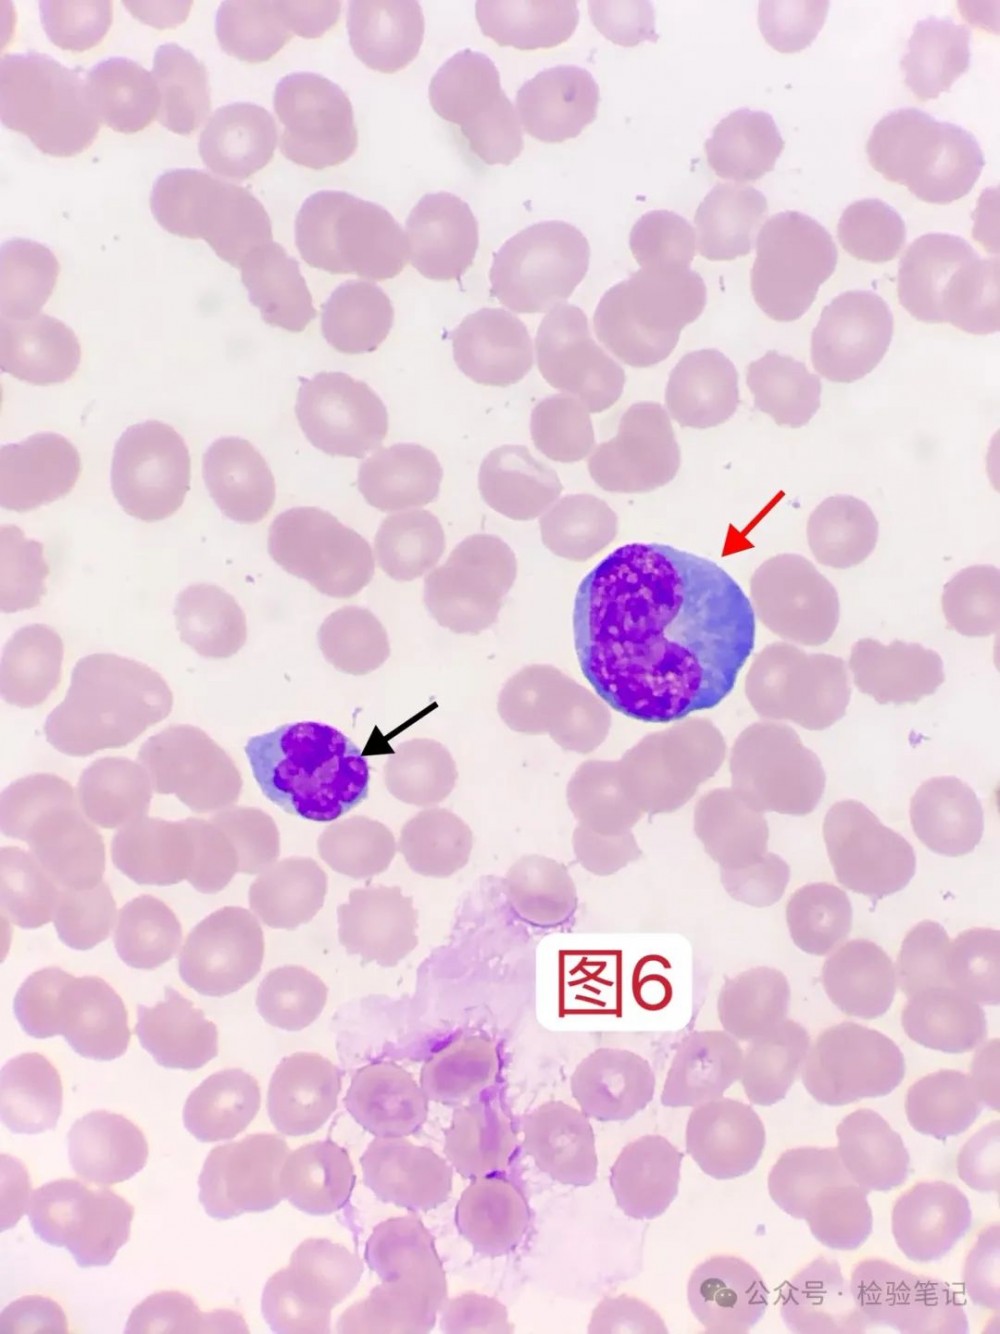

异淋16%、PLT低,EB+噬血?No!
01【前言】
谈起异淋>10%(专业名词:反应性淋巴细胞),首当其冲想到第一个便是EB病毒或传染性单核细胞增多症(IM)。
而传单时间拖久了,容易引发噬血细胞综合征(HLH),外周血三系可见降低。
现实中病例真会按常理出牌吗?
本案例就会告诉你,临床病例的复杂性以及多样性。
02【案例经过】
5月28号审核血分析报告时看到一例单核细胞比例46.5%,顿时来了兴趣,因为单核细胞比例≥20%,很有几率挖出血液病。
查看血球仪端界面,发现自己多想了,因为WDF散点图显示:淋巴细胞散点灰区,呈冲顶状(有说法像火箭升空样,又长又直)。

散点图放大看,更加清晰。

从散点图可猜想,异淋可能性最大,血液病嘛,暂且可排除。
如果单核细胞散点与淋巴细胞散点融合接壤了,呈冲顶,那就很可能是有点意思的血液病了。
所以掌握散点图,有时可以帮你快速锁定方向。
异淋还是原始?
一镜到底!

红色:反应性淋巴细胞
黑色:靠近胞核处有略微发白的高尔基体区(也有叫法“东方白”“鱼肚白”),这是反应性淋巴细胞一个小特点。
关于反应性淋巴细胞和单核细胞区别,看这个东方白可以鉴别。浆有东方白,不考虑单核!
与“东方白”相对应的,便是“朝阳红”,这便是AML-M2b特征,黄沙厚土出朝阳(解释:异常中性中幼粒细胞 胞浆的颗粒呈黄沙样、厚实的黄土样,放眼望去,一片土黄色,靠近胞核凹陷处出现粉红色区域,宛如朝阳初升。 出自:川渝流式联盟。出自:杨再林老师总结语录)

红色:反应性淋巴细胞
红色:反应性淋巴细胞
红色:反应性淋巴细胞
黑色:正常大小的淋巴细胞
此图有点“小巫见大巫”感觉。

红色:反应性淋巴细胞
黑色:中性杆状核粒细胞

红色:反应性淋巴细胞
绿色:胞浆可见少量细小的嗜天青颗粒,属正常现象
黑色:杂质

红色:反应性淋巴细胞
黑色:涂抹细胞,想起小时候的电灯泡

红色:反应性淋巴细胞
绿色:少量细小的嗜天青颗粒

红色:反应性淋巴细胞
黑色:单核细胞?可近胞核微微的发白区,着实令人徘徊异淋吗?个人考虑单核细胞。

红色:反应性淋巴细胞
黑色:胞核凸起,像不像曾经讲过的淋巴瘤细胞的棱角?

红色:反应性淋巴细胞

红色:反应性淋巴细胞

红色:反应性淋巴细胞

红色:反应性淋巴细胞
黑色:靠近胞核凹陷处的发白区域

红色:反应性淋巴细胞,胞浆不规则、裙边样
黑色:嗜碱性粒细胞

红色:反应性淋巴细胞,怎么样,还有胞核呈“O”形或胞核中间有个空洞的。

红色:反应性淋巴细胞

红色:反应性淋巴细胞

红色:反应性淋巴细胞,又来个胞核中间有空洞的。
03【案例分析】
(1)查看患者信息,男,16岁。分类计数,反应性淋巴细胞比例16%。血小板未见聚集,也确实比较少见。
提示传单?建议加做EB病毒?
且慢。
临床诊断写到:腰背部疼痛、单纯疱疹性神经痛。
就是这个诊断,让我直接pass了传单想法,加上该患者是长期随访的一个急性淋巴细胞白血病患者。(因为特殊病例不多,基本有些患者名字,都有印象)
所以,真相就是:患者为ALL化疗后随访,PLT 44×10⁹/L也能理解,由于化疗后会出现低白、免疫力下降情况,病毒也就有了可乘之机。
而对于病毒感染,会刺激淋巴细胞母细胞化,出现胞体变大、胞浆变蓝,也即是我们镜检看到的反应性淋巴细胞(异淋)。
(2)如果该患者不是ALL化疗,诊断也不是单纯疱疹感染,而是上呼吸道感染,此时可再问问症状是否发热、淋巴结肿大,再来提示传单或加做EB病毒,准确率会更高一些。
既然要体现镜检血片的价值,那就得看准来,临床才愿意相信形态的重要。
(3)外周血报告,异常白细胞形态:异淋16%,异常血小板形态:血小板数稍低,备注栏:考虑疱疹所致异淋。

写异淋,不写反应性淋巴细胞,是因为临床暂无法接受和理解检验一些名称术语的变更。
(4)临床用拭子取疱疹分泌物,外送第三方检测,带状疱疹病毒DNA定性:阳性。

(5)后期随访血常规图形、数值变化情况。
5月29号,末梢血,淋巴细胞散点灰区,无法分类。


5月30号,末梢血,淋巴细胞散点正常显示。


6月1号,静脉血,淋巴细胞散点正常显示,异淋比例6%。


可以发现,随着异淋比例的下降,淋巴细胞散点可正常显示。
04【总结】
当时发现这个病例时候,就有一种想法,异淋大于10%不一定完全等同于传单,还需结合一些临床的体格检查和症状再进行判断。
内容来源 | 检验笔记
图片来源 | veer、ibaotu
排版 | znm
审校 | 金宝

